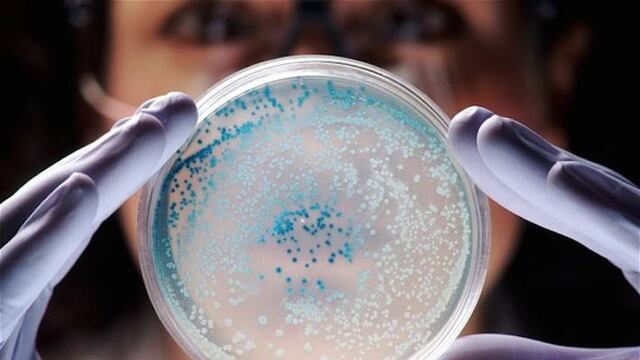
Las bacterias podrían ser resistentes a los antibióticos en algunos años

En entrevista con el ministro de Ciencia de Madrid, Pedro Duque, la directora del Laboratorio Europeo de Biología Molecular, Edith Heard, habló sobre las futuras pandemias.
De acuerdo con la especialista en epigenética, en 10 o 20 años las bacterias podrían volverse resistentes a los antibióticos.
La especialista Edith Heard señaló que las nuevas enfermedades podrían ser resistentes a los antibióticos y vacunas
Durante la entrevista, la directora mencionó que la comunidad científica ya tenía conocimiento de posibles pandemias dos años antes del Covid-19.
“Ya sabíamos que había riesgo, porque conocíamos otros virus como el del SARS. Necesitamos herramientas moleculares para entender qué está pasando”
Edith Heard
Edith también reveló que las bacterias se están volviendo resistentes a los antibióticos de forma acelerada.
“No es solo en los hospitales, puedes ver resistencias a los antibióticos en las bacterias del océano. Queremos entender por qué ocurre”
Edith Heard
Al ser directora del EMBL desde 2019, Edith Heard organizó una serie de presentaciones sobre las pandemias emergentes antes que la del Covid-19.
Durante las presentaciones, Edith señaló que las epidemias ocurrirán en áreas en que la acción humana destruye los ecosistemas.
Además, la experta explicó que las empresas especializadas en el sector salud redujeron la fabricación de antibióticos, esto provocará que existan menos fármacos.
Aunque en los últimos 100 años se ha duplicado la esperanza de vida gracias a los antibióticos y vacunas, dentro de 20 años, estos medicamentos no serán capaces de tratar las nuevas infecciones.
Actualmente, se utilizan medicamentos epigenéticos para tratar algunos tipos de cáncer y enfermedades causadas por bacterias
Por lo tanto, el Laboratorio Europeo de Biología Molecular pretende cubrir estos temas de salud mundial.
En la entrevista Edith Heard resaltó que al ganar el Premio L’Oréal-UNESCO había una esperanza de obtener fármacos epigenéticos para tratar algunos tipos de cáncer y otras enfermedades.
“Un fármaco epigenético es un medicamento que cambia estas modificaciones epigenéticas. Ya existen algunos, como la decitabina, que se utiliza para la leucemia mieloide aguda y el síndrome mielodisplásico”
Edith Heard
, Finalmente, Edith señala que los fármacos epigenéticos ya se están utilizando, “pero hace unos años yo pensaba que avanzaría más rápido”, concluyó.
La epigenética es un campo de la ciencia que estudia los cambios hereditarios causados por la activación y desactivación de los genes sin ningún cambio en la secuencia de ADN subyacente del organismo.